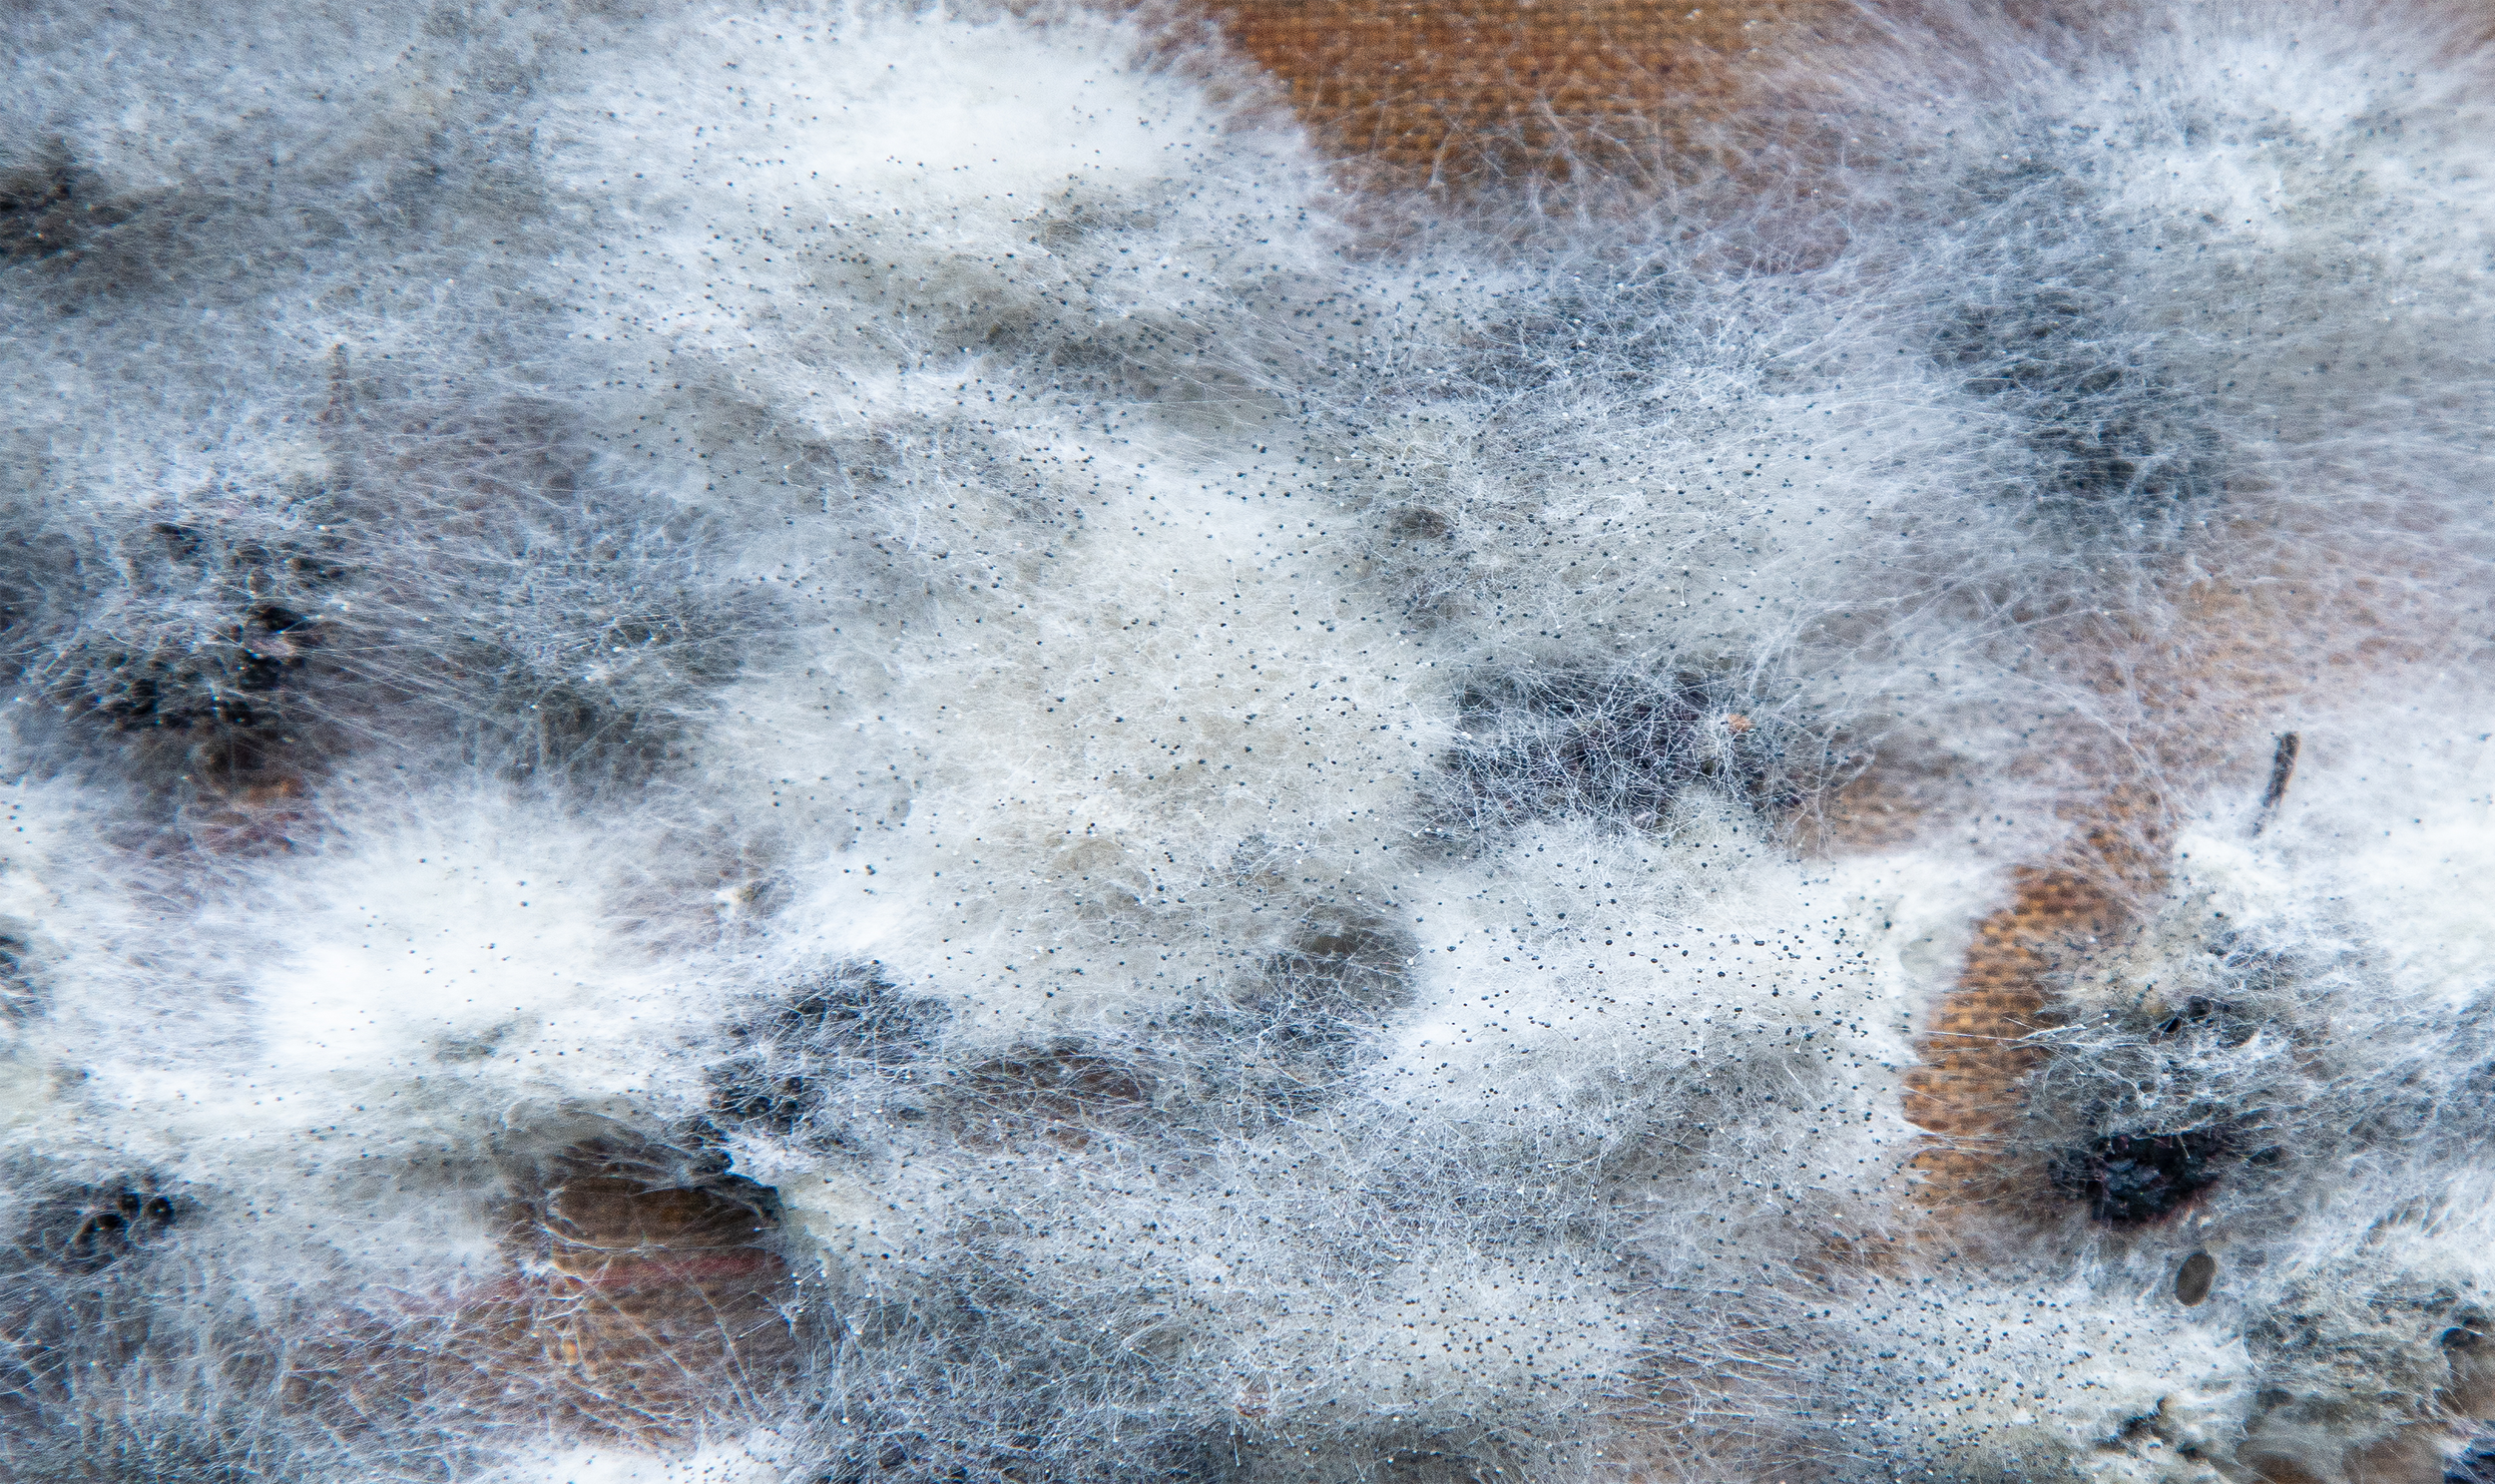
Close-up of mold or mildew growth on a surface, with fuzzy, web-like structures and small dark spores.

Without Moisture, Mold Cannot Grow, Making Moisture Control the Key to Mold Prevention.
Without Moisture, Mold Cannot Grow, Making Moisture Control the Key to Mold Prevention.
Why Building Science Matters
Building science is a multidisciplinary field that combines physics, chemistry, engineering, and architecture to understand how buildings perform. It focuses on optimizing the building enclosure to improve durability, energy efficiency, moisture control, and occupant comfort throughout the life of the structure.
Homes and Buildings function as a complete system rather than a collection of individual components. Building science evaluates the structures, recognizing that each part influences the performance of all the other components such as:
Without Moisture, Mold Cannot Grow, Making Moisture Control the Key to Mold Prevention.
Without Moisture, Mold Cannot Grow, Making Moisture Control the Key to Mold Prevention.
Building Materials - Building Envelope - Installation Detail - Ventilation Systems - Heating and Air Conditioning
Proudly Serving Western Washington
MOLD ISSUES?
Our Services
Read More About WA Energy Code

Air Leakage Testing (Blower Door Testing) is required by the Washington State Energy Code to verify air tightness. We provide certified testing for new construction and remodels, along with documentation needed for permit approval. This testing also helps improve energy efficiency and comfort.

Thermal Imaging & Heat Loss Detection
Thermal Imaging and Heat Loss Studies identify areas of energy loss within the building enclosure. Using infrared technology, we locate missing insulation, air leaks, and thermal deficiencies. This helps improve energy efficiency, comfort, and overall building performance.

Moisture Intrusion and Leak Detection
Moisture Intrusion and Leak Detection identifies sources of unwanted water entry within the building. We use advanced tools, including infrared imaging, to locate hidden moisture issues in walls, roofs, and assemblies. This service helps prevent damage, reduce mold risk, and support proper repairs.

Radiant Heating Pipe Location identifies the exact position of in-floor heating pipes before drilling, cutting, or renovations. Using infrared imaging, we map the system layout to help prevent damage and ensure safe, accurate work.
Why Northwest Infrared LLC
The purpose of a building science inspection is to assess and document the current condition of your home or building, while identifying underlying issues that may not be visible. It also provides clear guidance for proper repair or remediation.
Our inspections are conducted by independent, unbiased inspectors with no affiliation to any contractor services. This ensures our findings and recommendations are based solely on what’s best for your building, without any financial interest in the repair work.
How Building Science Inspections Can Help You?
OR
Prescriptive Energy Code Compliance For All Climate Zones in Washington
Air Leakage Control and Efficient Ventilation - 0.5 - 2.0 Energy Credits Options
WA Energy Code Air Intrusion Requirements
At Northwest Infrared LLC, we provide comprehensive blower door testing services designed to help builders, contractors, and homeowners achieve code compliance and improve overall building performance. Our services include accurate blower door testing to measure CFM50 and ACH50, as well as pre-drywall air leakage consultations to identify critical sealing opportunities early in the construction process. We offer advanced air leakage diagnostics using smoke testing and infrared imaging to locate hidden problem areas, along with code compliance testing to ensure your project meets Washington State energy requirements. Our team also provides post-construction verification testing, detailed reporting for inspections, and practical guidance to help you reach your target ACH50—whether you’re aiming for standard compliance or higher-performance goals like 2.0 ACH50 or better. In addition, we assist with Home Energy Score preparation, helping position your home for upcoming requirements. From initial consultation to final testing, we work closely with your team to keep projects on track and deliver reliable, results-driven solutions
Brent Foster, founder of Northwest Infrared LLC discussing Washington Energy Code and Air Intrusion




Mold

Is Mold Testing Important?
In Western Washington, mold is a natural and ever-present part of the environment. Mold spores are found in outdoor air year-round and are commonly present on soil, vegetation, trees, and organic materials. Because of this, mold spores routinely enter buildings through normal air exchange, open doors and windows, and everyday activity.
From a building science perspective, the presence of mold spores alone is not unusual or necessarily a concern. What matters is whether conditions inside the building allow mold to grow and amplify.
Mold growth requires moisture, suitable temperatures, and organic material, all of which are commonly found in buildings when moisture problems are present. When these conditions exist, mold can grow on materials such as wood, drywall, and insulation.
Limitations of Mold Testing
In many cases, mold testing (such as air sampling and laboratory analysis) has limited value because:
Mold spores are already present in both indoor and outdoor air
Results can vary significantly depending on time, location, and conditions
Identifying the species of mold does not change the need to correct the underlying moisture problem
If visible mold is present, testing is often unnecessary. The presence of growth already indicates a moisture issue that should be addressed.
Common Causes of Mold Growth
Occupants In The Home
Occupants are a primary source of moisture generation within a building. Everyday activities such as breathing, cooking, bathing, and cleaning release water vapor into the indoor air. This moisture increases indoor humidity levels and can contribute to condensation on cooler surfaces when not properly managed.
The amount of moisture generated is influenced by factors such as the number of occupants, occupant behavior, and the use of appliances like humidifiers. In tightly sealed or poorly ventilated buildings, this moisture can accumulate, creating conditions that support mold growth and material degradation.
From a building science perspective, effective moisture control requires a balance of ventilation, air sealing, and temperature management to prevent excess humidity from building up within the structure.
House Plants
Houseplants can be a significant source of indoor moisture. When plants are watered, a large portion of that moisture does not remain in the soil—instead, it evaporates into the surrounding air. In many cases, up to 90% of the water applied to houseplants can be released as water vapor through evaporation and plant transpiration.
This added moisture contributes to increased indoor humidity levels, particularly in enclosed or poorly ventilated spaces. When combined with other moisture sources, this can create conditions favorable for condensation and mold growth on building materials.
From a building science perspective, the impact of houseplants on indoor humidity should be considered as part of the overall moisture balance within the home.
Aquariums
Aquariums can be a continuous source of indoor moisture due to ongoing evaporation from the water surface. Unlike intermittent moisture sources, aquariums release water vapor into the air on a constant basis, especially when uncovered or exposed to warm indoor temperatures and air movement.
In enclosed or poorly ventilated spaces, this added moisture can elevate indoor humidity levels, increasing the potential for condensation on cooler surfaces and creating conditions that support mold growth.
From a building science perspective, aquariums should be considered a persistent moisture source and accounted for when evaluating indoor humidity and ventilation requirements.
Improperly Installed Insulation
Improperly installed insulation can contribute to moisture and humidity problems within a building. Insulation is designed to control heat flow, but when it is misaligned, compressed, or installed with gaps, it can allow temperature differences to develop across building surfaces.
These temperature variations can lead to condensation when warm, moisture laden air comes into contact with cooler surfaces inside walls, ceilings, or floors. In addition, poorly installed insulation can disrupt air barriers, allowing humid air to move into concealed spaces where moisture can accumulate. Over time, these conditions can contribute to elevated humidity levels, material degradation, and mold growth.
From a building science perspective, insulation must be properly installed in alignment with air and vapor control layers to effectively manage heat and moisture within the building enclosure.
Inadequate Ventilation Systems
Inadequate attic ventilation can contribute to moisture accumulation and elevated humidity levels within the building enclosure. Attics are designed to allow excess heat and moisture to escape, but when ventilation is insufficient or improperly configured, moisture-laden air can become trapped.
This moisture can originate from interior air leakage, occupant activities, or diffusion through building materials. When warm, humid air enters the attic and encounters cooler surfaces, condensation can occur on framing members, roof sheathing, and insulation. Over time, this can lead to material degradation, reduced insulation performance, and conditions that support mold growth. Proper attic ventilation is essential to control moisture movement and maintain the durability of the roof assembly.
Let’s begin the conversation.
Not sure where to start? We can help. Every home is different, and uncovering the root cause of building issues requires a detailed, building science based approach. Our inspections go beyond surface-level observations to identify what’s really happening within your home so you can make informed decisions and avoid unnecessary or costly repairs.
If you’re experiencing comfort issues, moisture concerns, or unexplained problems, we provide clear answers and practical guidance. Reach out with any questions or schedule your consultation today to take the first step toward improving your home.
Service Area
Infrared Thermography
Moisture Intrusion Inspection
Heat Loss Study
Air Leakage Testing